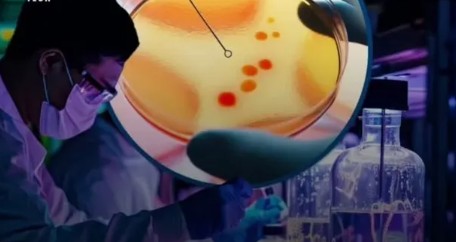

دانشمندان موسسه مطالعات زیستشناسی Salk ، توانستن در آزمایشگاه به صورت مصنوعی یه مولکول حیات آر ان ای رو بسازن و کپیهای دقیقی ازش بگیرن که در نتیجه یه آنزیم اصلی ساخته شد.
این تحقیق به نظریه “دنیای RNA” (RNA World) مرتبط است که پیشنهاد میکند در اوایل تاریخ زمین، RNA بهعنوان مولکولی کلیدی در پیدایش حیات نقش داشته است. مطالعه اخیر نشان میدهد که تکامل داروینی ممکن است در سطح مولکولهای RNA آغاز شده باشد و این مولکولها با بهبود تواناییهای خود، به سمت پیچیدگی و تنوع بیشتر حرکت کردهاند.
این یافتهها در مجله Proceedings of the National Academy of Sciences منتشر شده و به درک بهتر ما از منشأ حیات و چگونگی تکامل مولکولهای ساده به سیستمهای زیستی پیچیده کمک میکند.
این نظریه میگه که در اوایل تشکیل زمین، آر ان ای (خواهر تک رشتهای دی ان ای ) به دلیل واکنش های شیمیایی و تغییرات شدید طی میلیون ها سال به وجود میومده و برای ساخت حیات اولیه در زمین ضروری بوده.
جرالد جویس، نویسنده ارشد این مطالعه و رئیس موسسه Salk گفته: “این آزمایش نشون میده چطور میتونه حیات در آزمایشگاه یا در اصل هر جای دیگهای از جهان به صورت خود به خودی پدید بیاد.”
در این آزمایش دانشمندان تونستن شرایط مشابه با اون چیزی که در ابتدای تشکیل زمین وجود داشته رو در آزمایشگاه بسازن و بدین ترتیب لحظات اولیه شکلگیری حیات رو شبیهسازی کنن.
این کار به ما کمک میکنه تا بهتر درک کنیم که چطور میتونست از ترکیبات شیمیایی ساده اولین سیستمهای زنده شکل بگیرن.
دانشمندان موفق بهخلق حیات از هیچدر آزمایشگاه شدند!